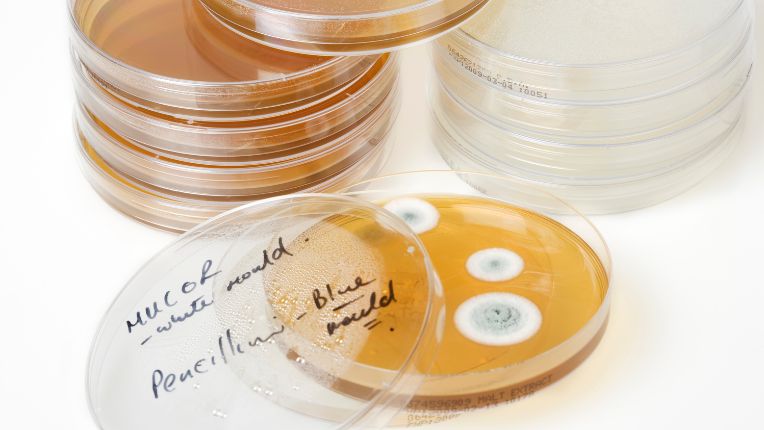
Pénicilline : définition, découverte, utilisation, dosage et allergie. Image d'une boîte de Petri avec des bactéries et des moisissures de Penicillium.

Pénicilline
✅️ Résumé : l'essentiel sur la pénicilline
-
La pénicilline est le plus vieil antibiotique découvert par l'être humain. Elle a sauvé beaucoup de vies humaines.
-
Elle a été découverte par le médecin britannique, Alexander Fleming, en 1928.
-
La pénicilline s'attaque à la paroi cellulaire de certaines bactéries.
-
Elle est utilisée par les médecins pour soigner certaines infections bactériennes.
-
La pénicilline doit être prise sous contrôle médical en raison des risques d'antibio-résistance.
-
Il existe des risques, rares, mais réels d'allergie à la pénicilline.
Cet article s’appuie sur des données validées par les autorités de santé (autorités sanitaires, base publique des médicaments, Assurance maladie) et sur l’expérience des médecins du groupe ELSAN. Pour toute prise de médicaments, veuillez demander conseil à votre professionel/lle de santé !
Définition : Qu'est-ce que la pénicilline ?
Le plus ancien médicament de la famille des antibiotiques
La pénicilline est une forme d'antibiotique appelée bêta-lactamine. Les bêta-lactamines ont un effet bactéricide. Elles sont utilisées contre les bactéries à gram positif et coques gram positifs :
-
Infections pneumococciques,
-
Infections streptococciques,
-
Syndrome de choc toxique.
et contre certaines bactéries cocci gram négatif comme les méningocoques.
Betalactamine
La pénicilline est le premier antibiotique découvert par l'être humain en 1929, mais son utilisation en thérapie humaine ne se fera qu'à partir des années 40.
La pénicilline peut donc avoir une action notamment sur ces maladies :
Quelles sont les différentes pénicillines ?
Parmi les pénicillines on compte :
-
Ampicilline.
-
Carbénicilline.
-
Dicloxacilline.
-
Nafcilline.
-
Oxacilline.
-
Pénicilline G.
-
Pénicilline V.
Qui a découvert la pénicilline ?
Qui a inventé la pénicilline ? Sir Alexander Fleming, 1928
C'est le médecin britannique, Alexander Fleming, qui a découvert la pénicilline en 1928, par hasard et sérendipité. La légende raconte qu'il a trouvé ses boîtes de Petri, contenant des staphylocoques, colonisées par des champignons provenant de la paillasse de son voisin. Il remarque que ces champignons, appelés Penicillium notatum, empêchent les bactéries de se développer. Il publie ses résultats sans que cela n'attire l'attention du grand public. Il se heurte surtout au fait qu'il lui semble difficile de cultiver ce champignon. Ce sont d'autres scientifiques qui aboutiront à l'utilisation à grande échelle de cet antibiotique. Il faut reconnaître au médecin français Ernest Duchesne d'avoir décrit l'effet de la pénicilline sur les bactéries dès 1897 !
Développement industriel pendant la Seconde guerre mondiale
Ce n'est qu'en 1940 qu'une équipe de trois scientifiques est parvenue à produire suffisamment de pénicilline. Elle est composée de Howard Florey, médecin et pharmacologue, d'Ernst Chain, chimiste, et de Norman Heatley, biologiste. Durant la Seconde guerre mondiale, Florey et Heatley partent aux USA pour poursuivre leurs travaux. Etant tombés, par hasard, sur un melon moisi, ils découvrent qu'il est plus intéressant de produire la pénicilline par ce biais ! Dès 1942, l'usine d'une compagnie pharmaceutique, Eli Lilly, parvenait à produire des milliards d'unités de cet antibiotique. En 1943, ils disposent d'assez de pénicilline pour l'essayer sur des soldats britanniques. Depuis, une industrialisation à grande échelle a été menée qui a fait de l'utilisation de cet antibiotique, une avancée considérable pour l'humanité. Fleming, Florey et Chain recevront le prix Nobel de physiologie et de médecine en 1945.
Place de la pénicilline aujourd’hui par rapport aux autres antibiotiques
L'amoxicilline -qui est une pénicilline de synthèse qui date du début des années 70- est l'antibiotique le plus prescrit en France, rappellent les autorités sanitaires. Il ne faut pas oublier que l'utilisation de la pénicilline, notamment, a été confrontée à la résistance des pneumocoques. Mais il semble que cette résistance ait diminué grâce, notamment, aux campagnes publiques appelant à ne pas utiliser excessivement les antibiotiques. Près de 100 ans après sa découverte, ce médicament est toujours utile.
Pourquoi utilise-t-on la pénicilline ?
À quoi sert la pénicilline ?
La pénicilline est prescrite par le ou la médecin pour soigner des infections.
Infections causées par des bactéries
Attention, il s'agit d'infections causées par des bactéries, pas par des virus. En outre, ce médicament cible un certain type de bactéries : les bactéries appelées Gram positif. On utilise cette bêta-lactamine couramment en médecine générale. Elle traite en particulier les infections :
-
des poumons,
-
des bronches,
-
du nez,
-
de la gorge,
-
des oreilles,
-
de l'appareil digestif,
-
de l'appareil urinaire,
-
des voies génitales,
-
des gencives,
-
des dents...
Seul (e) la ou le médecin est à même de déterminer si vous avec besoin d'un antibiotique et s'il est nécessaire de vous le prescrire.
Acide clavulanique, inhibiteur de bêtalactamase
Certaines bactéries détruisent l'effet de la pénicilline. C'est pour cela qu'on peut se voir prescrire, en même temps que l'amoxicilline, de l'acide clavulanique (un inhibiteur de bêtalactamase mieux connu sous le nom d'Augmentin) qui empêche sa destruction. D'autres association existent comme : ampicilline/sulbactam ou pipéracilline/tazobactam.
Comment la pénicilline agit-elle ?
Blocage de la paroi bactérienne
Schématiquement, on sait que la pénicilline est capable d'empêcher les bactéries qui ont une paroi cellulaire qui les protège, de former cette cette paroi. Cela entraîne la mort de ces bactéries.
Comment utilliser la pénicilline ?
Dosage
Le dosage de la pénicilline dépend de sa forme galénique, de l'infection, de l'âge et du poids du ou de la patiente.
A titre d'exemple, le phénoxyméthylpénicilline (mieux connu sous le nom de pénicilline V et commercialisé sous le nom Oracilline) présente cette posologie standard en cas d'angine aiguë streptococcique :
De 1 mois à 15 ans : 0,05 à 0,1 M UI/kg en 2 à 3 prises par jour pendant 6 jours.
A partir de 15 ans : 2 à 4 M UI en 2 à 3 prises par jour pendant 6 jours.
La pénicilline peut être prescrite par voie orale ou parentérale (injection).
En combien de temps la pénicilline ou les antibiotiques font-ils effet ?
D'une manière générale, les spécialistes s'accordent à dire que les antibiotiques ont un effet rapide sur les infections contre lesquelles ils ont été prescrits. De 24 à 48 heures. Les patientes et patients le voient en constatant la régression de leurs symptômes comme la fièvre, par exemple. Sur certaines bactéries, l'effet peut prendre plus de temps.
Effets secondaires de la pénicilline
Contre-indication : risque d'allergie grave
Il existe un risque d' allergie grave associé à la prise de pénicilline. il peut se traduire par :
-
une anaphylaxie,
-
de l'urticaire,
-
un œdème de Quincke.
Les réactions allergiques à la pénicilline sont considérées comme peu fréquentes. Il y en a de deux ordres :
-
une réaction quelques minutes ou heures après la prise comme :
-
urticaire,
-
angio-œdème,
-
rhinite,
-
conjonctivite,
-
bronchospasme,
-
réaction anaphylactique,
qui peuvent se révêler graves.
-
une réaction survenant plusieurs jours ou semaine après la prise comme :
-
manifestations cutanées généralement non compliquées.
Autre antibiotique en cas d'allergie ?
Céphalosporines
Un terrain allergique connu chez un ou une patiente doit mener à proposer, si possible, un autre antibiotique comme les céphalosporines, les carbapénèmes ou l'aztréonam. Un test d'allergie peut être proposé aux patients. Une désensibilisation peut être envisagée, mais elle pourrait n'être que temporaire.
Combien de temps dure une réaction allergique à un antibiotique ?
Cela dépend du type d'allergie. Certaines peuvent apparaître de façon immédiate comme un choc anaphylactique, un gonflement (œdème), d'autres plusieurs jours après comme une éruption cutanée. Une allergie à un traitement peut durer de quelques heures à plusieurs mois selon la situation. En cas de réaction allergique, n'hésitez pas à consulter !
Tableau des différentes variantes de pénicilline
|
Type de pénicilline |
Exemple |
Dénomination |
Nom commercial |
|
Benzylpénicilline |
Syphilis |
Pénicilline G |
Extencilline |
|
Phénoxyméthylpénicilline |
Angine aiguë Erysipèle, Traitement préventif |
Pénicilline V |
Oracilline |
|
Aminopénicillines |
Contre les bactéries Infections |
Amoxicilline |
Clamoxyl, Totapen |
|
Pénicilline M |
En cas |
Méticilline, |
|
|
Carboxypénicillines |
Maladies urinaires. |
Carbénicilline |
Pyopen |
Où trouver de la pénicilline ?
La pénicilline est prescrite par un ou une médecin. En raison des risques liés à l'antibiorésistance, notamment, ce médicament ne peut être délivré en vente libre en France. Il est d'ailleurs conseillé de s'en tenir à la dose prescrite et de rapporter le traitement non utilisé dans une pharmacie pour recyclage.
Les antibiotiques ne sont pas automatiques !
"L’usage inapproprié et trop souvent incorrect des antibiotiques a contribué au développement et à la dissémination de bactéries qui sont devenues résistantes aux antibiotiques", rappellent les autorités sanitaires. Ainsi, il y a eu 125 000 infections à bactéries multirésistantes en France en 2025. En outre, plus de 5 500 morts ont été attribuées aux infections à bactéries multi-résistantes. Pour lutter contre les effets délétères de l'antibiorésistances, spécialistes conseillent :
-
de se laver les mains fréquemment,
-
de veiller aux produits alimentaires et à leur mode de conservation,
-
de respecter les recommandations et obligations vaccinales,
-
de suivre les indications de votre médecin lorsqu'il doit vous prescrire un antibiotique : durée, dose, fréquence, ne pas partager votre traitement à quelqu'un d'autre, ne pas le réutiliser.
Quels médecins contacter ?
En règle générale, les médecins qui sont amené-e-s à prescrire de la pénicilline sont des médecins traitants, souvent des généralistes, mais aussi des spécialistes comme :
etc.
Sources
-
Assurance maladie, mise à jour 25/04/2025,
-
sante.fr, service public d'information, mise à jour 01/03/2022,
-
Base de données publique des médicaments, mise à jour 03/09/2025,
-
Vidal, mise à jour 21/06/2022.
Cet article médical a été écrit par un rédacteur expert santé et SEO (EEAT et YMYL), Pierre Luton, et relu et validé par un ou une médecin spécialiste en médecine générale au sein d’un établissement ELSAN, groupe leader de l’hospitalisation privée en France. Il a un but uniquement informatif et ne se substitue en aucun cas à l’avis de votre médecin, seul habilité à poser un diagnostic et à vous prescrire les médicaments dont vous avez besoin.
Pour établir un diagnostic médical précis et correspondant à votre cas personnel ou en savoir davantage et avoir plus d’informations sur votre pathologie, nous vous rappelons qu’il est indispensable de prendre contact et de consulter un médecin.
Vous trouverez ci-dessous, les praticiens et praticiennes généralistes au sein des hôpitaux privés ELSAN, qui vous reçoivent en RDV près de chez vous, dans l’un de nos établissements.
Auteur
Article écrit le 11/09/2025Nx:, vérifié par Pierre Luton, etablissement
Modifié le 24/10/2025Nx:, vérifié par Dr Philippe Aillères, Médecin urgentiste et directeur du bureau d'accueil des patients internationaux d'ELSAN
Vos questions fréquemment posées sur la pénicilline et sa présence dans les antibiotiques :
Quels sont les antibiotiques avec de la pénicilline ?
Les antibiotiques contenant de la pénicilline sont notamment :
-
Ampicilline.
-
Carbénicilline.
-
Dicloxacilline.
-
Nafcilline.
-
Oxacilline.
-
Pénicilline G.
-
Pénicilline V.
Quelle est la différence entre la pénicilline et l'amoxicilline ?
L'amoxicilline est une pénicilline de synthèse.
Quel est le nom commercial de la pénicilline ?
Il existe plusieurs noms commerciaux associés à la pénicilline comme :
-
Unacim,
-
Clamoxyl,
-
Extencilline,
-
Oracilline,
-
Totapen...
En combien de temps l'amoxicilline agit-elle ?
En règle générale, l'amoxicilline agit entre 24 et 48 heures après la prise.
Comment administrer la pénicilline ?
Certaines pénicillines peuvent être prises :
-
par voie orale (comme : amoxicilline et pénicilline V)
-
ou par injection (comme : pipéracilline/tazobactam).
-
D'autres (comme l'ampicilline) peuvent utiliser les deux voies.
Quel antibiotique utiliser en cas d'allergie à la pénicilline ?
En cas d'allergie connue, d'autres médicaments peuvent être prescrits à un ou une patiente :
-
céphalosporines,
-
carbapénèmes,
-
aztréonam.
Pénicilline ou pénissiline ?
La bonne orthographe est bien pénicilline qui vient du champignon : Penicillium.

